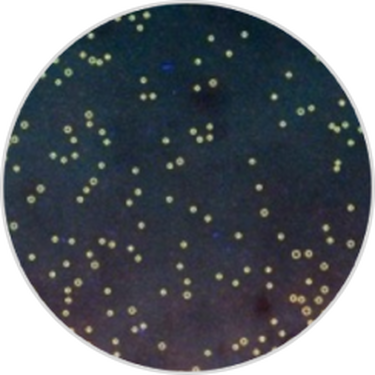

DISCOVER EVERYTHING YOU ALWAYS WANTED TO KNOW ABOUT YOUR SKIN
DISCOVER EVERYTHING YOU ALWAYS WANTED TO KNOW ABOUT YOUR SKIN
RECEIVE YOUR PERSONAL SKIN ANALYSIS ON 12 CLINICAL SKIN PARAMETERS
RECEIVE YOUR PERSONAL SKIN ANALYSIS
ON 12 CLINICAL SKIN PARAMETERS
FIND YOUR IDEAL SKINCARE SOLUTION
NOT READY TO GO IN-STORE?
Try E-Skin Expert, our most accurate online skincare diagnosis tool.

LANCÔME E-SKIN EXPERT
Discover our AI-powered skin diagnosis tool, drawing on our 85 years of skincare expertise. In just 2 minutes you'll receive a routine personalized to your skin's unique needs.
%20-%20Mobile.jpg?sw=430&sh=430&sm=cut&q=70)